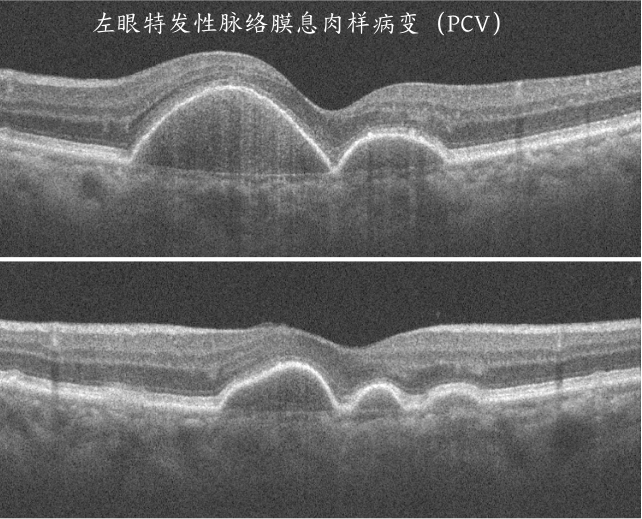

“医生快救救我!我的左眼突然又胀又痛,还恶心想吐,疼得我想撞墙,太难受了!”近日,71岁的魏阿姨一手紧紧捂着左眼,在无锡爱尔眼科医院综合眼病科的诊室里声音颤抖地哭诉着,痛苦的神情让人揪心。

谁能想到,就在1天前,魏阿姨才因右眼持续胀痛2个多月来就诊,当时的检查结果就已让她和家人忧心不已——右眼被确诊为新生血管青光眼绝对期,右眼视神经萎缩,然而左眼也是闭角型青光眼临床前期,同时合并左眼特发性脉络膜息肉样病变(PCV),双眼糖尿病性视网膜病变及双眼白内障,眼部问题堪称遭遇 “多重危机”。

考虑到魏阿姨眼部问题错综复杂,且部分病症已处于高危阶段,当即评估建议尽快手术治疗,并第一时间将手术安排在工作日第一天。于建春主任深知青光眼尤其是闭角型青光眼的“凶险”,术前特意为魏阿姨开具降眼压眼药水,反复叮嘱:“左眼一定要用药,就像颗‘定时炸弹’!一定要当心!不能关灯玩手机,避免瞳孔长时间散大诱发眼压升高;也不能一次性喝太多水而加重右眼病情;眼药水必须按时按量用,左眼的闭角型青光眼说发作就发作,千万不能掉以轻心!”
可让人始料未及的是,风险还是未能躲过。就在就诊后第二天清晨,魏阿姨被突发左眼剧烈胀痛惊醒,紧接着恶心、呕吐的症状接连出现,家人见状立刻送她再次来院。还在休假的于建春主任接到医院电话,紧急赶回医院为其检查,结果显示魏阿姨左眼眼压已飙升至 75.9mmHg。要知道,正常眼压范围仅为 10-21mmHg,这个数值早已远超危险阈值,正是闭角型青光眼急性大发作。“还好送医及时,要是再耽误哪怕几小时,很可能损伤视神经,甚至直接导致左眼失明。” 于建春主任一边安抚慌乱的家属,一边迅速为魏阿姨安排治疗,经过及时处理,她的疼痛症状才逐渐缓解。

回忆起这次突发经历,魏阿姨仍心有余悸,说到“我再也不想经历第二次了,太痛苦了!我的右眼能不能赶紧安排手术,我怕再出意外!”
于建春主任指出,青光眼是全球不可逆致盲的首因,尤其是急性闭角型青光眼,眼压可在短时间内急剧升高,迅速损伤视神经,治疗窗口极短。他特别提醒:有青光眼家族史、糖尿病、高血压的人群,应每年检查眼压与眼底;避免在暗环境中长时间用眼、一次性过量饮水;一旦出现眼胀、头痛、视力骤降、恶心呕吐等症状,必须立即就医—“拖延的每一分钟,都在逼近失明。”